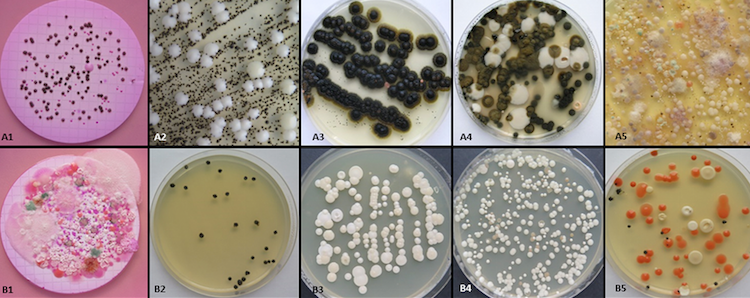

ಟ್ವೀಟ್ಗಳು
- ಟ್ವೀಟ್ಗಳು
- ಟ್ವೀಟ್ಗಳು & ಪ್ರತಿಕ್ರಿಯೆಗಳು
- ಮಾಧ್ಯಮ
@TEDx ತಡೆಹಿಡಿಯಲಾಗಿದೆ
ನೀವು ಖಚಿತವಾಗಿಯೂ ಈ ಟ್ವೀಟ್ಗಳನ್ನು ನೋಡಲು ಬಯಸುವಿರಾ? ಟ್ವೀಟ್ಗಳನ್ನು ನೋಡುವುದು @TEDx ಅವರನ್ನು ತಡೆತೆರವುಗೊಳಿಸುವುದಿಲ್ಲ.
-
Psychologists give parenting help for those displaced due the to war in Syria via bread deliveries: http://t.ted.com/L0DviQC
@TEDxManchesterpic.twitter.com/QhcsOa3r7t
-
How to protect New Zealand’s native birds? DIY tech: http://t.ted.com/KJbbBoO
@TEDxChCh@birdsongnz#PredatorFreeNZpic.twitter.com/T0XHGXJhPN
-
Le blob, un organisme unicellulaire qui apprend sans cerveau ! À voir sur
@TEDx avec Audrey Dussutour ~ https://youtu.be/47qiwqKRef0 pic.twitter.com/00Bw7lUapU
-
Today's
@TEDTalks is from@TEDxBerlin1!@jbbeacham searches for new particles w/@CERN's#LHC: http://t.ted.com/AEM3JTH pic.twitter.com/AeGSQBsMBw
-
At
@TEDxRiNo, a look into how gender identify plays into bathroom politics:http://t.ted.com/ntFHGb0 -
-
.
@RehabRobot designs robots that help people recover from stroke: http://t.ted.com/WcWlSN4 pic.twitter.com/wz4UynxDlS
-
A way to crowdsource ocean monitoring: http://t.ted.com/LFVvNnp
@TEDxWanChaipic.twitter.com/9Cehftpebk
-
-
"Living well with depression takes practice."
@JessicaGimeno@TEDxPilsenWomenhttp://t.ted.com/ErHgYnU -
How a TEDx organizer in Taiwan became friends with two TEDx organizers in Syria: http://t.ted.com/wkLXvL7 pic.twitter.com/39DkGyuZXx

-
Fungi that lives on the water drops of spiderwebs in the Atacama Desert & other weird organisms: http://t.ted.com/VIJeFyY pic.twitter.com/DkQakNEUfQ
-
"Being happy is a political act," says "wobbly comedian"
@chessmartinezhttp://t.ted.com/6u2xHKa -
-
.
@EmilyRYates on normalizing sex & disability at@TEDxStPeterPort: http://t.ted.com/BBjH7MX@Enhancetheuk -
"When you have child who is diagnosed w/ autism, you also have a family with
#autism."@LaChanHannonhttp://t.ted.com/mAiTSuk -
“Your attitude and who you are as a person is much more important than any mark on a test." http://t.ted.com/FY5PfJM pic.twitter.com/aAdKejgUCY

-
What to watch while the
#electoral college meets? This@TEDxStanford talk on why it's dysfunctional from Jack Rakovehttp://t.ted.com/BNFkUJk -
-
How do whales navigate? Geologist Travis Horton explores this question at
@TEDxChCh: http://t.ted.com/nIErwun pic.twitter.com/Cx94wMpOcW
ಲೋಡಿಂಗ್ ಸಮಯ ಸ್ವಲ್ಪ ತೆಗೆದುಕೊಳ್ಳುತ್ತಿರುವಂತೆನಿಸುತ್ತದೆ.
Twitter ಸಾಮರ್ಥ್ಯ ಮೀರಿರಬಹುದು ಅಥವಾ ಕ್ಷಣಿಕವಾದ ತೊಂದರೆಯನ್ನು ಅನುಭವಿಸುತ್ತಿರಬಹುದು. ಮತ್ತೆ ಪ್ರಯತ್ನಿಸಿ ಅಥವಾ ಹೆಚ್ಚಿನ ಮಾಹಿತಿಗೆ Twitter ಸ್ಥಿತಿಗೆ ಭೇಟಿ ನೀಡಿ.


 TEDx
TEDx
 Cécile Bruckmann
Cécile Bruckmann